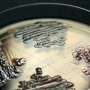

Dear Reader ,
The Application Builder and COMSOL Server Showcase >> http://goo.gl/ldYsLz
Build, manage, and deploy customized simulation apps throughout your organization with COMSOL Multiphysics, COMSOL Server, and the Application Builder. Check out the online showcase to learn more about how these tools optimize the design workflow: http://goo.gl/ldYsLz
Here is your customized Science X Newsletter for August 17, 2016:
Spotlight Stories Headlines
Astronomy & Space news
![]() | Researchers validate ancient astronomical structuresUniversity of Adelaide research has for the first time statistically proven that the earliest standing stone monuments of Britain, the great circles, were constructed specifically in line with the movements of the Sun and Moon, 5000 years ago. |
![]() | Beyond Neptune, a chunk of ice is orbiting the sun in the wrong directionBeyond the orbit of Neptune, the farthest recognized-planet from our sun, lies the mysteries population known as the Trans-Neptunian Object (TNOs). For years, astronomers have been discovering bodies and minor planets in this region which are influenced by Neptune's gravity, and orbit our sun at an average distance of 30 Astronomical Units. |
![]() | Professor wants to send our digital selves to the starsSetting foot on a distant planet… we've all dreamed about it at one time or another. And it has been a staple of science fiction for almost a century. Engage the warp dive, spool up the FLT, open a wormhole, or jump into the cryochamber. Next stop, Alpha Centauri (or some other star)! But when it comes to turning science fiction into science fact, there are certain unfortunate realities we have to contend with. For starters, none of the technology for faster-than-light travel exists! |
![]() | Supernova ejected from the pages of historyA new look at the debris from an exploded star in our galaxy has astronomers re-examining when the supernova actually happened. Recent observations of the supernova remnant called G11.2-0.3 with NASA's Chandra X-ray Observatory have stripped away its connection to an event recorded by the Chinese in 386 CE. |
![]() | Pro-telescope group: Don't close door to education benefitsBuilding a giant telescope atop Mauna Kea will come with educational opportunities that Hawaii shouldn't close the door to, the president of a Native Hawaiian group that supports the project said. |
![]() | Gaia's second anniversary marked by successes and challengesOperating in the depths of space, far beyond the Moon's orbit, ESA's Gaia spacecraft has now completed two years of a planned five-year survey of the sky. Despite a series of unexpected technical challenges, the mission is on track to complete the most detailed and complex mapping of the heavens ever undertaken. |
![]() | Two pairs of planets perform in the August twilightStep outside as the stars come out, look southwest, and you'll see an eye-catching pattern. For the next few days (August 17–22, 2016), bright orange Mars shines to the right of Saturn and the reddish star Antares. The three form a tall triangle that changes every night. |
![]() | One year to the 2017 total solar eclipseOne. More. Year. Quick; where will you be this time next year on August 21st, 2017? We're now just one year out this weekend from a fine total solar eclipse gracing the United States from coast to coast. If you think one year out is too early to start planning, well, umbraphiles (those who chase the shadow of the moon worldwide) have been planning to catch this one now for over a decade. |
![]() | How to dock CubeSatsThe miniature satellites known as CubeSats already play a variety of roles in space. In future they could also serve as the building blocks of other, larger missions by being docked together in orbit. |
![]() | NASA-funded balloon mission begins fourth campaignThe BARREL team is at Esrange Space Center near Kiruna, Sweden, launching a series of six scientific payloads on miniature scientific balloons. The BARREL team launched the first balloon of this campaign - the fourth for BARREL - on Aug. 13, 2016. The NASA-funded BARREL - which stands for Balloon Array for Radiation-belt Relativistic Electron Losses - primarily measures X-rays in Earth's atmosphere near the North and South poles. These X-rays are produced by electrons raining down into the atmosphere from two giant swaths of radiation that surround Earth, called the Van Allen belts. Learning about the radiation near Earth helps us to better protect our satellites. |
![]() | NASA prepares to launch first U.S. asteroid sample return missionNASA is preparing to launch its first mission to return a sample of an asteroid to Earth. The mission will help scientists investigate how planets formed and how life began, as well as improve our understanding of asteroids that could impact Earth. |
Technology news
![]() | Sodium-ion full battery's energy density approaches that of lithium-ion batteries(TechXplore)—Most of the sodium-ion batteries that have been developed so far have been half-cell batteries, meaning that the anode is made of a standard sodium metal. However, this standard sodium metal becomes highly active when exposed to oxygen or moisture, creating a safety hazard. For this reason, researchers have been exploring sodium-ion batteries in a full cell format, in which the anode is made of an alternative material. |
![]() | New lithium metal batteries could make smartphones, drones, and electric cars last twice as longAn MIT spinout is preparing to commercialize a novel rechargable lithium metal battery that offers double the energy capacity of the lithium ion batteries that power many of today's consumer electronics. |
![]() | Tesla isn't alone with cars that can nearly drive themselvesWith all the attention paid to Tesla Motors' Autopilot system, you'd think the company was the only one making cars that can almost drive themselves. But many automakers have rolled out cars that do what Teslas do. |
![]() | People ignore software security warnings up to 90 percent of the timeSoftware developers listen up: if you want people to pay attention to your security warnings on their computers or mobile devices, you need to make them pop up at better times. |
![]() | Interscatter enables first implanted devices, contact lenses, credit cards to 'talk' WiFiWe might be one step closer to the vision of Internet-connected wireless implanted devices. |
![]() | Giant helium-filled airship Airlander takes off for first timeA blimp-shaped, helium-filled airship considered the world's largest aircraft flew for the first time Wednesday with a short but historic jaunt over an airfield in central England. |
![]() | Project Alloy makes use of hand interaction with virtual world(Tech Xplore)—What do you know about merged reality? As the phrase suggests, we can safely guess it is a technology that makes it possible for physical and digital objects to co-exist. As interesting, the person engaging in merged reality can interact in real-time. |
Teaching machines to direct traffic through deep reinforcement learningRush hour—the dreaded time of day when traffic conditions seem bent on making you late. As your car slowly creeps in line behind countless others stuck at a stop light, you think to yourself, "Why aren't these lights changing faster?" Traffic control scientists have long tried to solve this signaling problem. Unfortunately, the complexity of traffic situations makes the job extremely hard. A recent study suggests that machines can learn how to plan traffic signals just right to reduce wait times and make traffic queues shorter. | |
WeChat sends China's Tencent profits surgingChinese Internet giant Tencent said Wednesday its profits jumped by 47 percent in the second quarter, buoyed by new users of its popular messaging service WeChat, gaming and digital content. | |
![]() | Lessons from FukushimaWhen you're an operator or engineer at a nuclear power plant, there are things you want to know long before you're faced with an emergency. |
![]() | "High-occupancy" vehicle (HOV) batteryIn lithium-ion batteries, a singly charged lithium atom (or "ion") flows between two electrodes while one electron is contributed to the electrical current in the external circuit. If too many lithium ions are intercalated (inserted between existing atomic layers), the electrode's atomic structure can distort, which usually limits the ability to recharge the battery. In a battery electrode composed of manganese oxide (Mn2O4), magnesium ions with two positive charges (Mg2+) could provide two electrons per intercalated ion—twice the electrical current if present at the same density—without irreversible distortion of the electrode material. This research showed that Mg2+ intercalation into Mn2O4 was extensive and reversible. |
![]() | New bendable concrete that is stronger and more durableNanyang Technological University (NTU Singapore) scientists from the NTU-JTC Industrial Infrastructure Innovation Centre (I³C) have invented a new type of concrete called ConFlexPave that is bendable yet stronger and longer lasting than regular concrete which is heavy, brittle and breaks under tension. |
![]() | Combating traffic congestion with advanced data analyticsFraunhofer IAO and Telefónica Deutschland are investigating how cell phone data could benefit traffic planning. |
Newspapers, digital subscription services can optimize profits with new modelFor decades, newspapers have relied on print advertising as their primary source of revenue. However, as newspaper readers continue to read more of their news online rather than in print, advertising revenue is dwindling for many newspapers. Now, researchers from the University of Missouri have developed a model that will enable newspapers to maximize their revenues from advertisements and subscriptions by offering a variety of subscription plans. The researchers' test of their new model at one major US newspaper indicated a potential increase of more 17 percent in the newspaper's profits. | |
![]() | The vents in your office aren't just pumping out airWe rely on our HVAC systems to keep us cool when it's hot and warm when it's cold—but that's not all they're doing. Current systems waste huge amounts of energy and hemorrhage money as a result. It's estimated that buildings consume more than 40% of our country's energy, and of that energy, nearly one third is wasted due to outdated, inefficient systems like heating and cooling. Not only is this hard on the environment, significantly contributing to greenhouse gas emissions, it's also hard on our wallets. Even cutting out half of these inefficiencies could lower the nation's annual energy bill by nearly $80 billion. |
![]() | Hacking the hackers? US spy agency at center of apparent breachThe US National Security Agency, which gained international notoriety in 2013 after Edward Snowden revealed its data snooping techniques, has itself become the target of an apparent data breach. |
Retailers look to high tech to engage visitors to their storeThe store, that basic building block of commerce, is emerging as a high-tech laboratory. | |
![]() | Troy Wolverton: Virtual world meets virtual reality as Minecraft heads to Oculus RiftIf you have an Oculus Rift, you can now use it to explore and build in the world of Minecraft. |
Intel ventures into virtual reality with headset and new studioIntel is diving head-first into virtual reality, announcing Tuesday at its annual developers forum in San Francisco that it is working on its own headset, collaborating with Microsoft to bring the medium to PCs, and opening a studio in Los Angeles focused on virtual reality content. | |
Amateur drone operators soon could face high-tech barriersSomething weird happened to Duncan Sinfield's drone shortly after he was told by a security guard to stop flying over a tech company's campus in the heart of Silicon Valley. | |
Reducing gas flares—and pollution—from oil productionLast year, dozens of major oil companies and oil-producing nations agreed to end the routine flaring of natural gas from wells by 2030. This burning off of uncaptured methane in addition to simply letting it escape into the air—a process called venting—releases pollutants and the greenhouse gases carbon dioxide and methane into the atmosphere. Now in ACS' journal Energy & Fuels, researchers report a strategy that could help producers work toward this goal. | |
![]() | More small businesses put focus on a mobile-first strategyGreenPal CEO Bryan Clayton came to realize he had to scrap his company's $90,000 website. |
FCC complaint: Baltimore police phone trackers disrupt callsCivil rights groups filed a federal complaint against the Baltimore Police Department's use of a portable technology that mimics cell towers to locate suspects and their cell phones. | |
![]() | Annual wind report confirms tech advancements, improved performance, and low energy pricesWind energy pricing remains attractive to utility and commercial purchasers, according to an annual report released by the U.S. Department of Energy and prepared by the Electricity Markets & Policy Group at Lawrence Berkeley National Laboratory (Berkeley Lab). Prices offered by newly built wind projects are averaging around 2¢/kWh, driven lower by technology advancements and cost reductions. |
![]() | Pinterest rolls out video ads at online bulletin boardPinterest on Wednesday introduced video ads as it moved to cash in on a growing appetite for videos at the popular online bulletin board. |
![]() | How do the blind watch the Olympics? NBC helps them hear itTwo people in a recording booth deep inside a Connecticut office park are helping millions of blind Americans feel part of the Olympics like never before. |
![]() | Railroads show little progress on key safety technologyMany commuter and freight railroads have made little progress installing safety technology designed to prevent deadly collisions and derailments despite a mandate from Congress, according to a government report released Wednesday. |
![]() | Review: Moments of awe, hours of tedium in 'No Man's Sky'If SpaceX CEO Elon Musk is right, our entire universe is a computer simulation. Fortunately for us, that sim is running on some high-powered gear, not to mention software sophisticated enough to generate something as weird and unpredictable as the human race. |
Review: These chargers can give a boost to students going back to schoolFor students heading back to school this month, keeping their phones, tablets and laptops charged up is important. | |
![]() | AT&T hikes prices for some plans, but raises data capsAT&T is joining Verizon in raising the prices of some of its data plans. |
![]() | Networking titan Cisco cuts 5,500 jobs as profit climbsCisco on Wednesday announced plans to cut seven percent of its global workforce as it shifts its focus from networking hardware to software and services. |
Medicine & Health news
![]() | Designer agent kills pain as well as morphine but may lack overdose riskInvestigators at the Stanford University School of Medicine and their collaborators at three other institutions have identified a novel compound that appears to exhibit painkilling power comparable to morphine but lacks that drug's most lethal property: respiratory suppression, which results in some 30,000 drug overdose deaths annually in the United States. |
![]() | TERRA, the RNAs that protect telomeresDespite their especially compact and inaccessible structure, telomeres transcribe information like the rest of the DNA. The RNAs resulting from this process are called TERRA, and their function is essential in preserving these protective structures. This is the conclusion of a new study by the Telomere and Telomerase Group at the Spanish National Cancer Research Centre (CNIO), which has also located the part of the human genome where these molecules are manufactured. |
![]() | Brain cell chatter persists even after dismantling key component of neurons' communication machineryNeuroscientists have long known that brain cells communicate with each other through the release of tiny bubbles packed with neurotransmitters—a fleet of vessels docked along neuronal ends ready to launch when a trigger arrives. |
Mouse study points way to shut down harmful immune response in lupusMolecules that scavenge debris from dying cells appear to halt the cycle of chronic inflammation in lupus, while also enhancing the body's ability to combat flu, according to Duke Health studies in mice. | |
![]() | Can't stand the heat? Study reveals how we work out if we're too hotWith temperatures soaring across the UK, our ability to detect and avoid places that are too warm is vital for regulating our body temperature. However, until now, little was known about the molecular mechanisms responsible for detecting warmth in the sensory neurons of our skin. |
![]() | Study paves way for steroid treatments with fewer side effectsAn improved therapy to replace essential steroids in the body is a step closer thanks to new research. |
![]() | Babies' spatial reasoning predicts later math skillsSpatial reasoning measured in infancy predicts how children do at math at four years of age, finds a new study published in Psychological Science. |
![]() | Genetic tests for potentially fatal heart anomaly can misdiagnose condition in black AmericansGenetic testing has greatly improved physicians' ability to detect potentially lethal heart anomalies among asymptomatic family members of people who suffer cardiac arrest or sudden cardiac death. |
![]() | Normalizing tumor oxygen supply could be key factor in the fight against cancerThe lack of oxygen in tumor cells changes the cells' gene expression, thereby contributing to the growth of cancer. This is the main conclusion of a research project led by professor Diether Lambrechts and Dr. Bernard Thienpont (VIB-KU Leuven), which was published in the renowned scientific journal Nature. The findings are far-reaching, as the study also proved that maintaining a proper oxygen supply in tumors inhibits these so-called 'epigenetic aberrations'. The paper's insights could eventually lead to new anti-cancer drugs that target blood vessels or the epigenetic aberrations. |
![]() | New insights into human genetic variation revealedPublished in today's edition of Nature, the research led by Dr Monkol Lek of the University of Sydney and Dr Daniel MacArthur of The Broad Institute of MIT and Harvard Universities reveals patterns of genetic variation worldwide by sequencing the exomes of 60,706 individuals with diverse geographic ancestries, including European, African, South Asian, East Asian and Latino populations. |
![]() | Scientists reveal why people with the ApoE4 gene are more susceptible to Alzheimer's diseaseFor decades, scientists have known that people with two copies of a gene called apolipoprotein E4 (ApoE4) are much more likely to have Alzheimer's disease at age 65 than the rest of the population. Now, researchers at the Salk Institute have identified a connection between ApoE4 and protein build-up associated with Alzheimer's that provides a possible biochemical explanation for how extra ApoE4 causes the disease. |
US and Mexican controls on precursor chemicals may reduce cocaine and meth use in the USIn December 2006, the USA regulated sodium permanganate, a chemical essential to the manufacture of cocaine. In March 2007, Mexico, the USA's primary source for methamphetamine, closed a chemical company accused of illicitly importing more than 60 tons of pseudoephedrine, a methamphetamine precursor chemical. A study published today by the scientific journal Addiction found that those two events were associated with large, extended reductions in cocaine users and methamphetamine users in the USA—impacts that have lasted approximately eight years so far. | |
Study finds average of two injuries every hour in the US from strollers, carriersAlthough strollers and carriers are typically used to safely transport children, injuries do occur while using these products. A study conducted by the Center for Injury Research and Policy of the Research Institute at Nationwide Children's Hospital found that, over a 21-year period from 1990 through 2010, almost 361,000 children aged 5 years and younger were treated in U.S. hospital emergency departments for stroller- or carrier-related injuries - that's about two children every hour. | |
![]() | New findings detail how beneficial bacteria in the nose suppress pathogenic bacteriaStaphylococcus aureus is a common colonizer of the human body. Although, one quarter of the U.S. population live with the bacteria and never get sick, having S. aureus present in the nostrils is a risk for infections that range in severity from mild skin to life- threatening MRSA infections. Research from the Forsyth Institute is providing insight into how harmless Corynebacterium species, bacterial members of the nasal and skin microbiome, help protect humans from disease. |
![]() | Opinion: How mindfulness can help you make better life choicesOne of the most important events in the British education calendar is approaching: A-level results day. Beyond A-levels, choosing what you want to do, or what you want to study are two of the big decisions in life. And, as such, they are not easy ones to make. You weigh up alternative options, and find a good number of reasons behind each of them. Many in the Twittersphere are already reliving their own results day memories with one user saying: "Aaaah I remember #Alevelresults day. Led me to a glittering English Literature degree which is why I work in IT". |
![]() | What's the best way to go to the toilet – squatting or sitting?Pauline Hanson's concern about the Australian Tax Office installing squat toilets to cater for its increasingly diverse workforce has prompted debate about the best way to go to the toilet: sitting or squatting. |
Disasters and kids – how to help them recoverLouisiana's historic floods have killed at least eight people. As many as 20,000 others have been rescued and thousands have been forced into shelters. | |
Probability data could better direct lymph node removal for thyroid cancerSurgeons operating on patients with advanced thyroid cancer are often conflicted when deciding how many lymph nodes they should remove to reduce the patient's risk of recurrence. | |
![]() | What we can learn about bones from Olympic gymnast's gruesome injuryEarlier this month, French gymnast Samir Ait Said broke his leg at the Rio Olympics while vaulting during the men's preliminaries. When Northeastern professor Sandra Shefelbine viewed the gruesome injury online afterward, her reaction mirrored that of most viewers. "Ouch!" she exclaimed. |
New life breathed into lung cancer study initiated 15 years agoIn the late 1990s, University of Kentucky Professor Douglas Andres found that mutations in a protein known as RIT1 could initiate cancer development in laboratory models. | |
![]() | A tiny wire with a memory to diagnose cancerEPFL researchers have used a nanowire to detect prostate cancer with greater accuracy than ever before. Their device is ten times more sensitive than any other biosensor available. |
Online fraud and romance scam victims find reporting the crime just as traumaticMany online fraud and romance scam victims say they found the experience of reporting the fraud and achieving justice as traumatic and harrowing as the victimisation itself, a new study by QUT criminologists has found. | |
Stay calm and drive on—tips to manage road rageWith parents and children gearing up to go back to school, you can expect there to be more cars on the road. While traffic can be extremely irritating, it is important to keep calm and avoid a road rage situation, said a Baylor College of Medicine expert. | |
![]() | Leukaemia blood testing has 'massive potential'Researchers at The University of Manchester have unlocked the potential of a new test which could revolutionise the way doctors diagnose and monitor a common childhood Leukaemia. |
![]() | New maths to predict dangerous hospital epidemicsMathematicians are now developing completely new statistical calculations on the world's fastest computers in order to predict how epidemics of dangerous hospital bacteria spread. |
![]() | Super-vaccine to guard against all strains of pneumococcal diseaseA new super-vaccine with the ability to eliminate all 90 known strains of the world's most deadly bacterial disease is being developed. |
Faster, higher, stronger—science shows why triple jumpers may be the ultimate OlympiansNo athletes arguably embody Pierre de Coubertin's Olympic motto – "faster, higher, stronger" – more fully than those competing in the triple jump. This dynamic track and field event comprises an approach run, followed by three consecutive phases: the hop, step and jump. The winner is the athlete whose rearmost mark in the sand is furthest from the takeoff board. | |
![]() | Understanding the fate of foodWhat exactly happens as we digest food and what are the implications for our health? Answering these questions will help design healthier foods that could curb the rising rates of obesity, diabetes and cardiovascular disease. |
![]() | Physical training and social support reduce frailty and malnutritionA training program for the reactivation of older and frail people established by MedUni Vienna has achieved remarkable success. It was revealed that physical training and addressing nutrition-relevant aspects with the aid of non-professional volunteers at home has had positive effects on the physical condition. Particularly the "social aspect" is of great significance. |
![]() | New study finds Sesame Street improves school readinessNew research, coauthored by Wellesley College economist Phillip B. Levine and University of Maryland economist Melissa Kearney, finds that greater access to Sesame Street in the show's early days led to improved early educational outcomes for children—and adds evidence to the argument that television can have a positive impact on society. While previous targeted studies conducted by the Educational Testing Services (ETS) in the early 1970s found that exposing children to Sesame Street increased preschoolers' test scores, the new study provides evidence that the generation of children who were of preschool age when the show aired did better in school once they got there. |
Want to win an Olympic final? Get in touch with your emotionsEvery sport has a different set of pressures. In team games such as football, individuals are expected to perform throughout the season and their performances are pored over every week. In other events, the pressure can be much more concentrated, with most attention falling on events that only happen once every few years, such as the Olympic Games. | |
![]() | Why beans, peas and lentils are the eco-friendly option for feeding the worldWe all know the score: current trends predict there will be 9.7 billion mouths to feed by 2050. Producing enough food without using more land, exacerbating climate change or putting more pressure on water, soil and energy reserves will be challenging. |
![]() | Society needs to challenge ageism more, says leading gericare expertAn interactive "dementia atlas" published online by the Department of Health needs to lead to society challenging ageism more, according to a leading expert on the care of older people at City University London. |
![]() | When you don't feel valued in a relationship, sleep suffersWe spend up to one-third of our life asleep, but not everyone sleeps well. For couples, it turns out how well you think your partner understands and cares for you is linked to how well you sleep. The results are published in Social Psychological and Personality Science. |
Low-income kids less likely to receive strabismus diagnosesChildren are less likely to be diagnosed with crossed eyes, a condition known as strabismus, if they live in poor communities, according to an analysis led by researchers at the University of Michigan's Kellogg Eye Center. | |
![]() | Aggressive lung cancer's aggressiveness may be its Achilles' heelResearchers at the University of Virginia School of Medicine have discovered a flaw in the armor of the most aggressive form of lung cancer, a weakness that doctors may be able to exploit to slow or even stop the disease. Remarkably, this vulnerability stems from the very aggressiveness that makes the cancer so deadly. |
![]() | Regenerative bandage heals diabetic wounds fasterAt some point in their lives, 15 percent of people with diabetes will develop a painful and hard-to-treat foot ulcer. Twenty-four percent of those affected will require a lower-leg amputation because of it. And, in some instances, what seems like a harmless sore might even lead to death. |
![]() | Body donations on the rise at US medical schoolsMany U.S. medical schools are seeing a surge in the number of people leaving their bodies to science, a trend attributed to rising funeral costs and growing acceptance of a practice long seen by some as ghoulish. |
Effectiveness of medical management vs revascularization for intermittent leg claudicationAmong patients with intermittent claudication, those who had revascularization had significantly improved walking function, better health-related quality of life, and fewer symptoms of claudication at 12 months compared with those who had medical management (walking program, smoking cessation counseling, and medications), according to a study published online by JAMA Surgery. | |
Study links self-reported childhood abuse to death in women years laterA study of a large number of middle-aged adults suggests self-reported childhood abuse by women was associated with an increased long-term risk of death, according to an article published online by JAMA Psychiatry. | |
![]() | Study examines use of antipsychotics early in pregnancy, risk of birth defectsA study of 1.3 million pregnant women suggests antipsychotic medication early in pregnancy was not associated with a meaningful increase in the risk of birth defects when other mitigating factors were considered, although the medication risperidone needs further research, according to a study published online by JAMA Psychiatry. |
Sex bias in human surgical clinical researchAn analysis of about 1,300 peer-reviewed research articles found that few studies included men and women equally, less than one-third performed data analysis by sex, and there was wide variation in inclusion and matching of the sexes among the specialties and the journals reviewed, according to a study published online by JAMA Surgery. | |
![]() | Sleep is key to college success(HealthDay)—It can be hard for college students to get enough sleep, and that can affect their physical and mental well-being, a sleep expert says. |
![]() | Large trial proposed to compare HCTZ, chlorthalidone(HealthDay)—A large randomized trial is being developed to compare the effectiveness of hydrochlorothiazide with chlorthalidone in Veterans Affairs (VA) patients, according to an Ideas and Opinions piece published online Aug. 16 in the Annals of Internal Medicine. |
![]() | Massive yellow fever vaccination campaign begins in CongoA massive emergency vaccination campaign began Wednesday in Congo against the largest yellow fever outbreak in decades, trying to stop its global spread. |
![]() | Roadblocks to research: Bioethicist addresses lack of HIV studies in pregnant womenUNC School of Medicine's Anne Lyerly is addressing the urgent need for effective HIV prevention and treatment for the estimated 1.5 million women worldwide with HIV who give birth each year. |
Fungus causing fatal infections in hospitalized patients has unique growth patternsThe multidrug-resistant yeast Candida auris, which has caused fatal infections in some hospitalized patients, has at least two different growth patterns and some of its strains are as capable of causing disease as the most invasive type of yeast called Candida albicans, according to a study published this week in mSphere, an open access journal from the American Society for Microbiology. | |
Survey shows broad support for national precision medicine studyIn a recent survey designed to measure public attitudes about the Precision Medicine Initiative (PMI) Cohort Program, a majority of respondents expressed willingness to participate in the nationwide research effort. The findings were published online in PLOS ONE by a team of National Institutes of Health researchers. | |
Anemic adults may have a higher risk of death after strokeAnemia, a lack of red blood cells, may be linked to a higher risk of death in older adults who have had a stroke, according to new research in Journal of the American Heart Association, the Open Access Journal of the American Heart Association/American Stroke Association. | |
![]() | Calcium supplements linked to dementia risk in women with certain health conditionsAccording to a new study, calcium supplements may be associated with an increased risk of dementia in older women who have had a stroke or other signs of cerebrovascular disease. The research is published in the August 17, 2016, online issue of Neurology, the medical journal of the American Academy of Neurology. |
![]() | For sensation-seekers, the color red can elicit rebelliousness, study findsAs anyone who has driven a car or crossed a busy street knows, colors play a significant role in influencing people's interactions with the world around them. And the color red, in particular, elicits the highest level of compliance for conformity with social norms. |
Study quantifies risk factors for preterm birthA significant portion of preterm births might be avoided by reducing or eliminating three major risk factors. | |
![]() | New standard helps ensure accurate clinical measurements of HER2 breast cancer geneA new measurement standard developed by the National Institute of Standards of Technology (NIST) has been used successfully by the Frederick National Laboratory for Cancer Research to check the performance of next-generation DNA-sequencing technologies for evaluating gene variations associated with an increased risk of breast cancer. |
![]() | How are dreaded multidrug-resistant pathogens brought into hospitals?According to National Reference Center for Surveillance of Nosocomial Infections esti-mates, up to 15,000 patients die of hospital-acquired infections in Germany every year. Here, multidrug-resistant bacteria, against which common antibiotics are no longer effec-tive, play a major role. But where do these pathogens come from? In largest study of its kind in Europe, DZIF scientists from the University of Cologne investigated this question and discovered that almost ten percent of patients admitted into hospitals already bring these dreaded pathogens along with them from home. |
![]() | Study reveals ethnic differences in mental illness severity when hospitalizedChinese and South Asian patients in Ontario experience more severe mental illness at the time of hospital admission than other patients, according to a new study that examined the association between illness severity and ethnicity. |
Two percent testosterone solution improves sex drive and energy levels in men with hypogonadismFor men with hypogonadism, a condition in which the body does not produce enough testosterone, low sex drive and fatigue are common symptoms. For these men treatment with a 2% testosterone solution (T-sol) can be effective therapy. In a six-month open-label study of patients receiving T-sol, published in The Journal of Urology, researchers noted improvement of low sex drive and low energy symptoms, and did not identify new safety concerns. | |
Free sports physicals reveal high rates of obesity in student athletesResearchers at Thomas Jefferson University found similar rates of obesity and high blood pressure readings in student-athletes as would be expected in the general adolescent population, which may suggest that participation in athletics does not protect against these conditions. They published their findings in The Journal of Pediatrics. | |
![]() | Music demonstrated to alleviate cancer patients' symptomsWe've all heard of laughter being the best medicine, but what about music? |
Researchers shed light on vascular growth factors in thyroid eye diseaseResearchers from the Schepens Eye Research Institute of Massachusetts Eye and Ear have identified new underlying mechanisms of proptosis, or bulging of the eyes, in patients with acute thyroid eye disease. In a report published online in the journal Ophthalmology, the researchers describe vascular growth factors causing an abnormal proliferation of blood vessels, as well as the rare formation of lymphatic vessels, that may contribute to the dangerous swelling and inflammation that occurs in the orbits of these patients. The findings point to new potential targets for non-surgical therapies to decompress the eye in the acute phase of thyroid eye disease. | |
![]() | Fluoride consumption linked to diabetes using mathematical modelsWater fluoridation prevents dental cavities, which are a costly public health concern. But despite the benefits supplemental water fluoridation remains a controversial subject. Some indicate it may cause long term health problems, but studies reporting side effects have been minimal or inconclusive. The long-term effects of ingested fluoride remain unclear. |
![]() | Acetaminophen does not aggravate children's asthmaContrary to earlier reports, giving acetaminophen (Tylenol, etc.) for pain and fever does not worsen asthma in young children with the condition, concludes a randomized trial in the August 18 New England Journal of Medicine. |
![]() | Study links two genes to breast cancer survivalTesting for the activity of two genes could pick out women who are at increased risk of dying from their breast cancers, suggests a new study of almost 2,000 patients. |
The gender divide in urology: Surgeon gender shapes the clinical landscapeAlthough female certified urologists are still a minority within the specialty, they perform many more procedures on women than their male colleagues, who perform more procedures on men than their female colleagues. As more women opt to specialize in urology, attention needs to be paid to the way gender shapes the clinical landscape, report researchers in The Journal of Urology. | |
New 'food group'? Ketone esters improve endurance exercise and cognitive functionNew research published online in The FASEB Journal shows that in rats, a substance called a ketone ester significantly increase exercise endurance, cognitive function and energy levels in the heart at high workloads. Ketone esters are small organic chemicals that provide energy for the heart, brain and skeletal muscle in a highly efficient way, but are typically produced by the body only during periods of food scarcity and are not naturally present in typical modern diets. | |
Post-transplant anxiety linked to complex instructions, caregiver empathySome anxiety is perfectly normal for kidney transplant patients, but new research suggests that medical staff can help patients feel more at ease when they leave the hospital and that could decrease the chances they'll be readmitted. | |
![]() | OnabotulinumtoxinA effect lasts in overactive bladder(HealthDay)—OnabotulinumtoxinA treatment is safe and effective for long-term treatment of overactive bladder syndrome, according to a study published in the September issue of The Journal of Urology. |
![]() | Antenatal steroids don't cut morbidity in preterm twins(HealthDay)—Antenatal administration of corticosteroids is not associated with a reduction in the incidence of respiratory distress syndrome (RDS) in preterm twins, according to research published in the September issue of Obstetrics & Gynecology. |
![]() | Residents often order perceived unnecessary lab tests(HealthDay)—Residents frequently order perceived unnecessary inpatient laboratory tests, according to a study published online Aug. 13 in the Journal of Hospital Medicine. |
![]() | Physician-perceived frailty tied to warfarin discontinuation(HealthDay)—Physician-perceived frailty and low life expectancy are the main reasons for warfarin discontinuation in elderly patients, according to a study published online July 29 in the Journal of Thrombosis and Haemostasis. |
![]() | Novel tracer safely and effectively maps sentinel lymph nodes in breast cancer patientsDetermining whether breast cancer has spread to sentinel lymph nodes (SLN) is key to prognosis and treatment, making SLN mapping critical. The blue dyes commonly used to identify SLNs spread quickly to other nodes and is poorly retained by the SLNs (less than five minutes). This requires the surgeon to identify SLNs quickly. Allergic reaction to the dyes has also been a concern. |
New Phase 1 clinical trial to test Durvalumab in pediatric patientsIn an innovative, first-in-pediatrics study, available only at Children's Hospital Los Angeles (CHLA), researchers will be enrolling children between 1 and 18 years of age who have certain types of relapsed or treatment-resistant cancer. | |
![]() | Homelessness linked to poor antipsychotic medication adherenceSFU health sciences researcher Stefanie Rezansoff has published a new study on the treatment of serious mental illnesses among people who are homeless. This is the first study to investigate adherence to antipsychotic medication in this population. |
![]() | Study: Catalog of DNA variations helps find roots of diseaseA huge catalog of human DNA is helping researchers find tiny glitches that cause disease, in part by pointing out some false leads. |
Guatemala confirms first Zika-linked microcephaly, paralysisThe main hospital in Guatemala's capital on Wednesday confirmed the country's first case of a Zika-linked birth defect in a newborn and two cases of a related nerve disorder. | |
![]() | Developing biosensor devices for better cancer diagnosisDiagnosing cancer early on can greatly improve a patient's prognosis. Biopsies and screening are the most common and accurate means currently used to identify cancer markers in the blood. But samples have to be sent to central laboratories for analysis, making the process expensive and time-consuming. Procedures for taking samples can also be invasive and distressing for the patient. |
Researchers working to advance aging researchMayo Clinic, along with other members of the Geroscience Network, has published six manuscripts that map strategies for taking new drugs that target processes underlying aging into clinical trials. Researchers believe that these agents hold promise for treating multiple age-related diseases and disabilities. The articles appear today in The Journals of Gerontology: Series A - Biological Sciences and Medical Sciences. | |
![]() | Hawaii authorities urge awareness of raw food riskHawaii authorities are urging diners to be aware of the risks of eating raw and undercooked food after they traced a hepatitis A outbreak to frozen scallops served raw at a sushi restaurant chain. |
![]() | How the brain developsThe developmental period from childhood to young adulthood is marked by profound physical, social, and emotional changes. But exactly how those changes are reflected in the brain remains something of a mystery. |
![]() | WHY IT MATTERS: Opioid epidemicTHE ISSUE: More Americans are dying from opioids than at any time in recent history, with overdose deaths hitting a peak of 28,000 in 2014. That amounts to 78 Americans dying from an opioid overdose every day, according to the Centers for Disease Control and Prevention. The CDC uses opioid as an umbrella term for synthetic painkillers and for drugs derived naturally from opium (known more specifically as opiates), such a heroin. |
![]() | Research helps treatment of heart attacks and angina in Aboriginal peopleResearch carried out by The University of Western Australia into the management of Aboriginal heart patients has found that while treatment is improving, more work is needed to ensure that rural patients are getting treatments that match those that are recommended. |
13 die from suspected toxic liquor in IndiaAt least 13 people died Wednesday, a local official said, after they apparently drank toxic homemade liquor in India's eastern Bihar—despite a state-wide ban on alcohol. | |
ACA coverage hikes prescription drug use, lowers out-of-pocket spending, study findsPeople who gained health coverage following the implementation of the federal Affordable Care Act's coverage expansion sharply increased their use of prescription drugs, while their out-of-pocket spending for medications dropped significantly, according to a new RAND Corporation study. | |
Association for Molecular Pathology establishes new standard for clinical utility of molecular DxThe Association for Molecular Pathology (AMP), the premier global, non-profit organization serving molecular diagnostic professionals, today announced a new report that addresses the challenges in defining the clinical utility of molecular diagnostics for inherited diseases and cancer. The manuscript titled "The Spectrum of Clinical Utilities in Molecular Pathology Testing Procedures for Inherited Conditions and Cancer: A Report of the Association for Molecular Pathology" has been released online ahead of publication in the September 2016 issue of the Journal of Molecular Diagnostics. | |
Life expectancy in some CKD patients could be improved with nephron-sparing treatmentA nephron-sparing treatment selection for small renal masses based on the nephrometry score may improve life expectancy in patients with mild or moderate chronic kidney disease, a study published in the August 2016 issue of the American Journal of Roentgenology said. | |
Scientists discover possible new weapon in the fight against gum diseaseIf you hate going to the dentist, here's some good news. New research published online in The FASEB Journal, shows that melanocortin agonism may effectively control the inflammation that often occurs in gum tissue, which when unchecked, ultimately accelerates tooth and bone loss. This research involving mice, opens the door to a new class of treatments for gum disease. | |
![]() | New guidelines for managing hyperthyroidism and other causes of thyrotoxicosisNew evidence-based recommendations from the American Thyroid Association (ATA) provide guidance to clinicians in the management of patients with all forms of thyrotoxicosis (excessively high thyroid hormone activity), including hyperthyroidism. Appropriate treatment of thyrotoxicosis requires an accurate diagnosis, and the 124 recommendations presented in the new Guidelines help define current best practices for patient evaluation, diagnosis, and treatment. The Guidelines, published in Thyroid, a peer-reviewed journal from Mary Ann Liebert, Inc., publishers and the official journal of the ATA, are available free on the Thyroid website. |
Nigeria starts emergency polio vaccinationsNigeria said Wednesday it has launched a mass campaign of emergency polio vaccinations after reporting two new cases of the disease earlier in August. | |
Biology news
![]() | CRISPR-Cas9 breaks genes better if you disrupt DNA repairCRISPR-Cas9 is the go-to technique for knocking out genes in human cell lines to discover what the genes do, but the efficiency with which it disables genes can vary immensely. |
![]() | Climate change alters the rules of sperm competition in the seaThe impact of climate change on global seawater conditions could change the rules of sperm competition for many important marine species, a pioneering new study has shown. |
![]() | Sea habits of migratory birds highlight conservation need in the Canary CurrentScientists have tracked the behaviour of seabirds migrating across the Atlantic to better understand how these animals use the marine environment and find out where they might come into conflict with human activities. |
![]() | Stay out, stray stem cellsDespite the hubbub about pluripotent stem cells' potential applications, when it comes time to introduce products into patients, the stem cells are actually impurities that need to be removed. |
![]() | Blocking a human branched DNA enzyme offers new ways of targeting a crucial enzyme family for cancerAn international team of scientists has discovered how compounds block flap endonuclease 1 (FEN1) - a crucial enzyme class in the DNA damage response and potential target for cancer treatment. |
![]() | Long-term exposure to female scents changes courtship behavior in male miceFew things are as interesting to a male mouse as the scent of a female. Pheromones released by females draw the attention of male mice and trigger courtship and mating behavior. |
![]() | Environmental datasets help researchers double the number of microbial phyla known to be infected by virusesThe number of microbes in, on, and around the planet - on the order of a nonillion, or 1030 - is estimated to outnumber the stars in the Milky Way. Microbes are known to play crucial roles in regulating carbon fixation, as well as maintaining global cycles involving nitrogen, sulfur, and phosphorus and other nutrients, but the majority of them remain uncultured and unknown. The U.S. Department of Energy (DOE) is targeting this "microbial dark matter" to better understand the planet's microbial diversity and glean from nature lessons that can be applied toward energy and environmental challenges. |
![]() | New techniques boost understanding of how fish fins became fingersOne of the great transformations required for the descendants of fish to become creatures that could walk on land was the replacement of long, elegant fin rays by fingers and toes. In the Aug. 17, 2016 issue of Nature, scientists from the University of Chicago show that the same cells that make fin rays in fish play a central role in forming the fingers and toes of four-legged creatures. |
![]() | Two Barbados bird species enter the select club of string-pullersThe Barbados bullfinch and Carib grackle can pass the popular animal cognition test of string-pulling, but this ability may be unrelated to performance on six other cognitive tests, according a study published August 17, 2016 in the open-access journal PLOS ONE by Jean-Nicolas Audet from McGill University, Canada, and colleagues. |
![]() | Flowering meadows benefit humankindThe more it swarms, crawls and flies the better it is for humans. This is the finding of a study published in Nature. More than 60 researchers from a number of universities were involved, including the Technical University of Munich, the Institute of Plant Sciences at the University of Bern and the Senckenberg Biodiversity and Climate Research Centre in Frankfurt. A diverse ecosystem populated by many species from all levels of the food chain provides higher levels of ecosystem services, the team reports. Even rather unpopular insects and invisible soil-dwelling organisms are important in maintaining a wide range of ecosystem services. The results underline the necessity of maintaining species-rich ecosystems for the good of humanity. |
![]() | Pesticide-resistant whitefly could 'devastate' many US cropsA tiny, invasive whitefly that is resistant to pesticides and carries crop-devastating viruses has been found outdoors in the United States for the first time, raising concerns among fruit and vegetable growers. |
![]() | A molecular alarm clock awakens resting ovulesAt the start of reproductive life an ovary contains, on average, several thousands of immature ovules in a resting state that can last for several decades. But how does each resting ovule know that it is time to prepare for ovulation? In a study published in the latest issue of Nature Communications, researchers at Instituto Gulbenkian de Ciencia (IGC; Portugal), at University of Algarve (Portugal), and at University at Albany (USA) discovered in the fruit fly a molecular "alarm clock" that tells resting ovules when is the right time to wake up. Defects in this alarm clock result in female fertility problems. |
![]() | Real-time visualization of the function of bone-resorbing cells within animalsResearchers of Osaka University have discovered a way to visualize sites where bone-resorbing cells (osteoclasts) were in the process of resorbing bone in living mice. This real-time visualization of changes in osteoclast localization and activity allowed the successful measurement of bone resorption intensity. Since this enables simple and quick access to information on the activity of osteoclasts, this discovery will contribute to the early diagnosis of affected areas and the development of new therapeutic drugs. |
Poaching patrol—new ranger methods decrease illegal activitiesEcologists from the University of York have tested a new method to detect and decrease wildlife poaching, using data to better predict where illegal activities occur in protected areas. | |
![]() | Researchers discover a special power in wheatA new photosynthesis discovery at The University of Queensland may help breed faster-growing wheat crops that are better adapted to hotter, drier climates. |
![]() | Mix of marine zones matters most for prey fishIn a first-of-its-kind study, James Cook University scientists have discovered a mosaic mix of marine zones could benefit populations of prey fishes. |
![]() | And one root said to the other root, 'Don't I know you from somewhere?'The global population of cycad plants is facing increasing threats, but research-driven decisions are rarely achievable for conservationists. The general lack of applied research on cycad plants has been discussed for decades, yet many of the roughly 340 species have never been the subject of ecology or horticulture experimental work. The paucity of empirical information places decision-makers and managers at a disadvantage when attempting to proactively conserve a species. |
![]() | Cultivating soybeans to combat the kudzu bugAdam Bray has spent a lot of time with kudzu bugs. "At night I would see them crawling when I closed my eyes," he jokes. |
![]() | New report on Arctic species that will help guide future research and management decisionsLittle did Charles Dickens know when he penned "Barnaby Rudge" in 1840 that the name of his character Dolly Varden would spawn the moniker for a red-spotted trout. Following the book's publication, a "Dolly Varden"came to describe a dress of sheer muslin worn over a bright petticoat. Years later, when the distinctive spots of Salvelinus malma, a distant relative of salmon, brought to scientists' minds that familiar fabric pattern, a new name for the fish was born. |
Sulfoxaflor found to be less harmful to insect predators than broad-spectrum insecticidesA new study appearing in the Journal of Economic Entomology has found that the selective insecticide sulfoxaflor is just as effective at controlling soybean aphids (Aphis glycines) as broad-spectrum insecticides, without causing significant harm to some beneficial predators of the aphid. | |
![]() | New century brings new challenges for national parksWhen we look back 100 years from now, wonders Linda Bilmes, what will we be glad we did today? |
This email is a free service of Science X Network
You received this email because you subscribed to our list.
If you no longer want to receive this email use the link below to unsubscribe.
https://sciencex.com/profile/nwletter/
You are subscribed as jmabs1@gmail.com

No comments:
Post a Comment